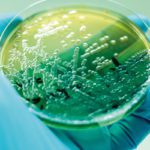
Using microbes to remove microplastics Pseudomonas aeruginosa colonies collected on a laboratory plate

Sponsored Content: Sludge dewatering efficiency
With increasing demand for reliable dewatering of effluent in municipal sewage treatment plants, GEA has stepped up with its class-leading environmental decanters designed for high clarification performance and maximum solid thickening.
Sponsored Content: Reusing wash water at equipment hire firm
MSE Systems has provided equipment hire firm Sunbelt Rentals with a fully automated wastewater treatment system following a successful rental and testing period in 2020.
The firm was asked to provide a system that would dramatically reduce the amount of fresh water used by Sunbelt Rentals when cleaning the dirty Trakway panels ready for use by new customers. Trakway is a series of panels laid down to create access to fields and sites that are usually inaccessible to vehicles and pedestrians.
Slim SAF meets SEPA spec
Technology from wastewater treatment specialist WPL has been selected by Scottish Water to deliver enhanced ammonia removal at a village treatment works.
Progress made but too many still falling short, says EA on environmental performance of...
The Environment Agency released its annual report on the environmental performance of England’s nine water and sewerage companies on 13 July.
Whilst there were improvements...
Firms appointed by utility to support £5 billion infrastructure programme in Scotland
Utility firm Scottish Water has appointed a network of companies that it says will enhance water and wastewater services, and support a forecasted £1...
High-tech greywater reuse for exclusive residences
A next-generation smart greywater-recycling system has been installed at a residential development in one of London’s most exclusive neighbourhoods. Supplied by water infrastructure specialist...
Report urges food and beverage industry to adopt water best practice
The reputational and financial risks of the mismanagement of water and wastewater systems is the subject of a new report published today (17 June)....
Selecting the appropriate reverse osmosis system
Stuart Malcolm, technical sales manager for SOCOTEC’s Water Treatment & Equipment team, answers a series of frequently asked questions regarding the importance of selecting...
Sponsored content: New firm has the tech for tightening consents and nutrient removal
Engineering and construction contractor The Trant Group has announced the launch of Te-Tech Process Solutions, a new company providing innovative products for water and...
Sponsored content: Clamp-on flowmeters for sand and grit-trap optimisation
Ultrasonic flowmeter measures turbidity and flow for grit trap control at wastewater treatment plants, "reducing pump and scraper operation by up to 85%"
In classic...
Collaborative summit to explore future of FOG
A collaborative event will bring together water, wastewater and sustainability experts to explore new ways of tackling fat, oil and grease (FOG) in sewers...
Comment: Smart water reuse and flood management technology “could be a vital strategic water...
Comment from water technology firm SDS
Water infrastructure planners should aim to exploit emergent digitally-controlled rainwater storage and recycling technologies to contribute substantially to water...
Sponsored content: Centrifuge reduces emissions
GEA’s centrifuge technology for dewatering sludge is playing a key role in helping waste company Biffa’s recycling plants reduce plastic pollution and CO2 emissions in the UK.
Sponsored content: Microplastic and pollution removal partnership extended
Following a partnership maintained through AMP6, water technology firm Eliquo Hydrok and filtration expert Mecana have extended their mutually exclusive representation agreement for the UK, despite Covid interfering with the ability to conclude and toast the new agreement in person!
Using microbes to remove microplastics
Researchers at Hong Kong Polytechnic University have developed a seemingly new technique to trap and recover microplastics.
An enduring threat to water?
Dr Ian Ross of professional services firm Tetra Tech, and the author of the Emerging Contaminants Handbook, discusses the emergence of PFAS as contaminants of concern in the UK
AI successfully detects blockage formations for Wessex Water
Machine-learning technology trialled on part of Wessex Water’s sewerage network has identified early forming sewer blockages in real-time with a 92% accuracy rate, whilst...
£40m Water Breakthrough Challenge opens for entries on 6 May
The £40 million Water Breakthrough Challenge will promote innovation and collaboration between the water sector and partner organisations, says water industry regulator Ofwat.
The Water...
Measures to reduce harm from storm overflows now law
Measures to reduce sewage discharges from storm overflows became a legal requirement on 29 March, as part of "an ambitious agenda to build back...
Ammonia removal technology selected for Scottish site
Technology from wastewater treatment specialist WPL has been selected by Scottish Water to deliver enhanced ammonia removal at a village treatment works.
Tightening...